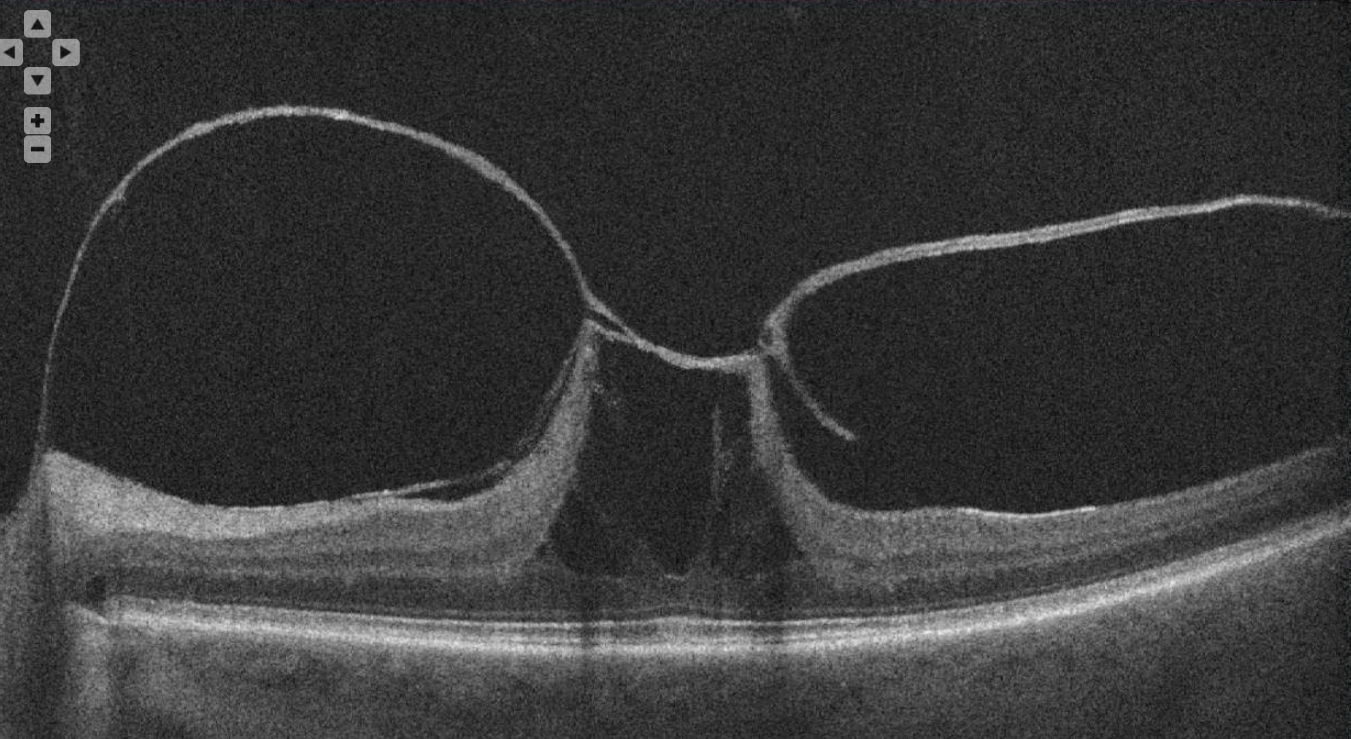

This popular HBO sitcom features an episode where Ben Stiller has his "retina scratched."

What is Curb your enthusisasm?
The vitreous occupies this amount of volume in the eye.
What is 4mL (4.4mL)?
The incidence of a posterior vitreous detachment by age 70.
90%
This condition can occur from increased pressure to the head and neck.
What is valsalva retinopathy?
A restaurant previously co-owned by Chef Lee and a rapper.
What is Fring's?
The main character in this film is from a major Canadian city.
Whats is Vancouver?
Collagen & Hyaluronic Acid
What makes up (constitutes) the vitreous?
The incidence of a retinal tear following Posterior vitreous detachment.
15%
This optic nerve condition can cause a maculopathy
What is optic disc maculopathy OR optic disc pit?
Susur was a finalist on the second season of this Bravo TV program
What is Top Chef Masters?
The famous tag line this character was known for saying in the "sixth sense."

What is "I see dead people."
This OCT image shows a retinal condition impacted by the vitreous.
What is VMT?
This image reveal 2 different retinal findings.

Whats is lattice degeneration & retinal holes?
This OCT shows a retinal finding associated w/ thyroid eye disease.

What are choroidal folds?
Kai, Levi & Jet
Who are Chef Lee's sons?
In this Tom Cruise film, his character, John Anderton had his eyes exchanged for his safety.

What is the Minority Report?
This vascular structure regresses in cloquet's canal.
What is the tunica vasculosa lentis?
50% of patients with this vitreous finding have diabetes.

What is asteroid hyalosis?
The dense material (and vitreous cells) in this UWF image should not be confused with routine floaters, because this material is consistent with a life-threatening condition.

What is Primary Intraocular Lymphoma?
This Chef Lee establishment is located in the Soho Hotel
What is Luckee?
This hollywood film featuring Sean Connery was the first to feature OCT imaging.
What is Entrapment?
These types of vitreous opacities/floaters are most amenable to yag vitreolysis (name 2)
Focal (weiss ring), well defined.
The patient is this image has this stage of diabetic retinopathy

What is proliferative diabetic retinopathy (PDR)?
In this this colour fundus photography, the yellow dots represent a particular cell type
What are vitreous hyalocytes?
Chef Lee's favourite ingredient to work with.
What is garlic?